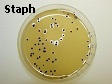
S aureus on Baird Parker Agar

Safety in the Laboratory
Handling hazardous chemicals | Storage chemicals | Flammability | Lab rules | Fire Triangle
Handling hazardous chemicals:
- A list of all chemicals used and stored should be kept; also a MSDS (Material Safety Data Sheet) for each chemical must be kept on the premises.
- Know your hazard classes: Flammable agents are CLASS 3 (liquids) and CLASS 4 (solids). Oxidising agents and organic peroxides are listed as CLASS 5. Poisons are CLASS 6. Corrosive substances are CLASS 8. Check the bottle label and icon to see which class the chemical belongs. Refer to your Laboratory Techniques page.
- It is unsafe to store certain chemicals in close proximity with one another, e.g. never store oxidising chemicals such as chlorates, nitrates, perchlorates, with reducing chemicals or with organic materials. Hazardous combinations of chemicals must be avoided to reduce the risk of fire, explosion and/or evolution of fumes.
- Some other examples of hazardous chemicals are: bromine liquid; sodium metal (stored under naptha or paraffin), potassium metal, phosphorous metal (stored under water). These should be isolated and stored separately from each other. For example, sodium reacts violently with water, with the evolution of hydrogen and possibly fire.
- It is advisable to store large quantities (200 litres or more) of flammable chemicals in a specially built registered chemical storeroom, with fireproofing and adequate drainage, as per local city building bye-laws and your company insurance requirements.
- A Safety Shower is a must in any laboratory that handles toxic or flammable chemicals, acids and strong alkalies.
- A Fire Blanket is a must in laboratories that handle flammable solvents or strong oxidisers.
- Peroxide formation can be very dangerous when the formation is unintentional or unexpected.
BACK TO TOP OF PAGE
Storage
| List of some Oxidising Chemicals | List of some Reducing Chemicals |
|---|---|
| chlorates | ammonia, ammonium hydroxide |
| chromates | carbon |
| chromium trioxide | metals |
| dichromates | metal hydrides |
| halogens | nitrites |
| hydrogen peroxide | organic compounds |
| nitric acid | phosphorus |
| nitrates | silicon |
| perchlorates | sulphur |
| peroxides | |
| permanganates | |
| persulphates |
Never store any oxidising chemical next to any reducing chemical
BACK TO TOP OF PAGE
Flammability terms of chemical substances:
- Flash Point is the minimum temperature at which the vapour pressure of a liquid is sufficient to form an ignitable flash (explosive) mixture with air near the surface of the liquid. Once ignited, it becomes self-extinguishable. Refer to the Explosive Limits of mixtures of gases or vapour.
- Fire Point is the minimum temperature at which the vapour or gas mixture of a liquid with air is sufficient to maintain a flame or continue to burn near the surface of the liquid. This temperature is about 5°C above its Flash Point. Refer to the Explosive Limits of mixtures of gases or vapour.
- Ignition Point or Autoignition temperature is the minimum temperature necessary for a self-sustained combustion (fire) of a substance in the absence of any external source of ignition (e.g. flame, heat, spark, etc.).
- Upper and Lower Explosive Limits or Upper and Lower Flammable Range is the range of concentration (by volume) of the chemical vapour in air for which a flame (i.e.combustion) can take place or propagate. If the mixture is too rich with the vapour (i.e. it exceeds the upper limit), or if insufficient air (oxygen) is available, then combustion (fire) can not take place. If the mixture is too lean (i.e. below the lower limit), then combustion (fire) can not take place.
- Pyrophoric chemicals are those chemicals or mixtures that will ignite spontaneously (burn or explode) when exposed to air. The list of pyrophoric chemicals has been removed from this website by the Webmaster for security reasons.
- Water-reactive chemicals are those chemicals or mixtures that will react violently when exposed to water or aqueous mixtures. The list has been removed from this website by the Webmaster for security reasons.
- Shock-sensitive chemicals are those chemicals or mixtures that will react violently when exposed to a mechanical shock or impact; e.g. a motor vehicle's safety air-bag.
| Chemical name | Flash Point °C | (Auto) Ignition Temperature °C | Flammable Limits, percent volume in air | Boiling Point °C |
|---|---|---|---|---|
| acetone | -19 | 540 | 3 LEL - 13 UEL | 56 |
| carbon bisulphide | -30 | 90 | 1 LEL - 44 UEL | 46 |
| cyclohexane | -18 | 260 | 1 LEL - 8 UEL | 81 |
| diethyl ether | -45 | 160 | 2 LEL - 48 UEL | 34 |
| ethanol | 12 | 360 | 3 LEL - 19 UEL | 78 |
| isopropyl alcohol | 12 | 400 | 2 LEL - 12 UEL | 82 |
| methanol | 11 | 380 | 6 LEL - 37 UEL | 64 |
| toluene | 4 | 530 | 1 LEL - 7 UEL | 111 |
| p-xylene | 25 | 530 | 1 LEL - 7 UEL | 132 |
LEL is Lower Explosive Limit, in air and UEL is Upper Explosive Limit, in air
BACK TO TOP OF PAGE
| Chemical name | Vapour Density, air=1 | TLV, in ppm | Flammable Limits, percent volume in air | Auto-ignition temperature °C |
|---|---|---|---|---|
| acetylene | 0.9 | toxic | 3 LEL - 80 UEL | 300 |
| ammonia | 0.6 | 50 | 16 LEL - 25 UEL | 650* |
| arsine | 2.7 | 0.05 | 5 LEL - 70 UEL | 280 |
| butane | 2.0 | 600 | 1 LEL - 9 UEL | 370 |
| carbon dioxide | 1.5 | 5000 | non-explosive | nil |
| carbon monoxide | 0.97 | 50 | 12 LEL - 74 UEL | 610 |
| chlorine | 3.2 | 1 | ? | ? |
| ethane | 1.0 | ? | 2 LEL - 12 UEL | 530 |
| hydrogen | 0.1 | ? | 4 LEL - 74 UEL | 570 |
| hydrogen sulphide | 1.2 | 10 | 4 LEL - 46 UEL | 270 |
| "Handigas"(propane/butane) | 1.7 | ? | 2 LEL - 10 UEL | 480 |
| methane | 0.6 | toxic | 4 LEL - 13 UEL | 600 |
| methyl chloride | 1.8 | toxic | 7 LEL - 17 UEL | 600 |
| naphtha fractions | 0.7 to 2.5 | 500 | 1 LEL - 7 UEL | 300 |
| nitrogen | 0.97 | ? | non-explosive | nil |
| oxygen | 1.1 | * | supports combustion | - |
| pentane | ? | 1000 | 2 LEL - 9 UEL | 280 |
| phosphine | 1.2 | 0.3 | ? | ? |
| sulphur dioxide | 2.2 | 5 | non-explosive | nil |
Critical Oxygen concentrations in air:
- normal concentration = 20.8%
- deficient = 16.5%
- minimum for life = 18%
- for prevention of combustion (burning) = less than 10%
BACK TO TOP OF PAGE
Some general laboratory rules are:
- The playing of games or other similar activities in the laboratory is prohibited.
- Protective clothing and other safety equipment must be used at all times. It is there for your protection!
- No unauthorised persons to enter the laboratory.
- Know your company or local authority emergency procedures.
- Know where your fire-fighting equipment is kept.
- Know your Company's Safety Policy and Disciplinary Code.
- Never leave a flame (Bunsen burner or an AA flame) unattended.
- Practice Good Housekeeping at all times....there is a place for everything and everything in its place.
- Know the properties of the chemical that you are using, namely its: flammability, reactivity, corrosiveness, toxicity and stability........refer to its Material Safety Data Sheet or the R and S phrases on the bottle label.
- Remove any spillages immediately using the correct procedures, refer to its Material Safety Data Sheet or the R and S phrases on the bottle label.
- Discard all broken, chipped, and badly scratched glassware into a separate waste container.
- Discard all reagents/solutions that are not in labelled bottles or are out of date, into an appropriate waste container.
- Wash your hands frequently to remove any traces of chemicals.
- Eating, drinking or smoking is not permitted in laboratories (except where tasting is done in food laboratories where organoleptic examinations are done under controlled conditions.
- ALWAYS WEAR SAFETY GLASSES OR GOGGLES whilst working in the laboratory!
- IF A GAS FIRE OCCURS, THEN IMMEDIATELY TURN OFF THE SUPPLY OF GAS e.g. at valve of gas cylinder.
- IF A SOLVENT FIRE OCCURS, THEN ALELOW IT TO SAFELY BURN ITSELF OUT, MAKING SURE THAT THERE ARE NO OTHER COMBUSTIBLES IN THE VICINITY, because a fire extinguisher woUELd just blow the burning liquids in all directions!
- CARE AND MAINTENANCE OF GLASSWARE: Refer to your Laboratory Techniques page.
- Never leave vessels unattended when evaporation of liquids is in progress,; the vessel (glass, porcelain) may crack or explode as dryness condition is approached if the heat source is not adjusted correctly; lower the temperature gradually as the liquid level decreases.
- Always use caution when removing glassware from a heat source and avoid placing on a cold or damp surface, sudden temperature changes may cause the glassware to explode or crack.
- Never place a red-hot item from the furnace directly into a desiccator for cooling, as the thick glass of the desiccator wiLEL violently expand and crack; cool the item temporarily on the outside or top of the furnace and then place into desiccator.
- Always heat or cool vessels slowly to prevent thermal shocks to the vessel.
- Always diffuse the heat source (Bunsen Burner) by using a metal gauze, or air/water bath or sand bath.
- Always use anti-bumping devices (to prevent localised superheating) in the vessel (such as powdered pumice, glass beads) when rapid heating of the vessel and its contents are required.
- When using glass or metal mechanical stirrers in a glass vessel, always predetermine the height of the stirrer before use to ensure there is no contact between the stirrer blade and the bottom or sides of the vessel; for magnetic stirrers regularly check the speed (rpm) to prevent splashes.
- Never try to pull a glass thermometer out of a rubber bung, rather carefully cut away the bung (wear gloves or some other sort of hand protection).
- The use of water, or glycerol (glycerin) is recommended on both tubing and rubber bungs when inserting glass tubing into a bung (wear gloves or some other sort of hand protection).
- SAFETY INSPECTIONS: These are performed regularly by a nominated and elected (by non-management staff) Safety Representative in accordance with the mandatory legal requirements of the OSHA laws.
A safety checklist to follow soon.
BACK TO TOP OF PAGE
The Fire Triangle where all three sides must connect in order to cause a fire/explosion!

Deflagration is when a hot burning material heats an adjacent cold material and ignites it.
Combustion is basically oxidation (i.e. reaction with oxygen) to cause a fire or explosion.
A flame can propagate (speed of a flame) from one point to another in a matter of 1 to 3 metres per second (depending uopon the substance (chemical) burning).